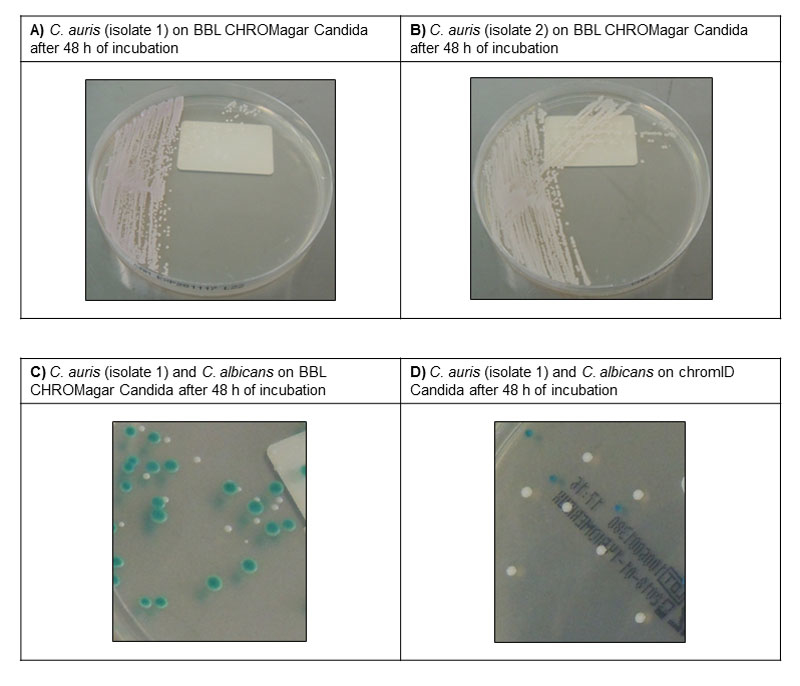

First case of Candida auris in Switzerland: discussion about preventive strategies
DOI: https://doi.org/10.4414/smw.2018.14622
Arnaud
Riata, Dionysios
Neofytosb, Alix T.
Costec, Stephan
Harbarthbd, Alain
Bizzinie, Bruno
Grandbastiene, Jerome
Puginf, Frederic
Lamothcg
aService of Laboratory Medicine, Geneva University Hospitals and Faculty of Medicine, Switzerland
bService of Infectious Diseases, Geneva University Hospitals and Faculty of Medicine, Switzerland
cInstitute of Microbiology, Lausanne University Hospital, Switzerland
dInfection Control Programme, Geneva University Hospitals and Faculty of Medicine, Switzerland
eService of Hospital Preventive Medicine, Lausanne University Hospital, Switzerland
fIntensive Care Unit, Geneva University Hospitals and Faculty of Medicine, Switzerland
gInfectious Diseases Service, Department of Medicine, Lausanne University Hospital, Switzerland
Introduction
Candida spp. are a major cause of bloodstream infections associated with high mortality. The epidemiology of Candida infections is evolving, with a progressive shift from Candida albicans to non-albicans Candida spp. characterised by decreased susceptibility to azoles [1]. Most concerning is Candida auris, a previously unrecognised Candida species, which emerged as a novel cause of candidaemia and invasive candidiasis in 2009 [2, 3]. This new fungal pathogen is a serious public health problem because of its potential for nosocomial transmission and its ability to develop resistance to all antifungal drug classes [2, 4]. Outbreaks of strains with different clonal origins have been reported from all continents [2, 4]. C. auris has become the fifth most common cause of candidaemia in India and multiple cases have been reported in Pakistan, South Korea, Israel, Kuwait, South Africa, Kenya, United States, Colombia and Venezuela [4, 5]. In Europe, major outbreaks have occurred in London (UK) and Valencia (Spain) [6, 7]. However, C. auris has rarely been reported in other European countries, where it has been isolated only from travellers from endemic regions [4]. This epidemiological situation raises important concerns about strategies that should be implemented to prevent the importation and spread of C. auris in countries that are currently spared. We present here an update of the situation in Switzerland and our recommended approach in terms of preventive strategies.
Candida auris in Switzerland
In Switzerland, the first case of C. auris was documented in Geneva in October 2017. A 74-year-old female who was on vacation in north-eastern Spain was admitted to a local hospital with severe community-acquired pneumonia requiring mechanical ventilation. C. auris was isolated from tracheal aspirates and the patient was treated with meropenem and fluconazole. At day 18 of the hospital stay, she was transferred to Geneva with acute respiratory distress syndrome. Screening at various sites (tracheal aspirates, groin, auditory canal, urine) was positive for C. auris, whereas multiple sets of blood cultures were negative for yeasts. After initial improvement and antibiotic discontinuation, the patient developed septic shock of unknown origin and ultimately died. C. auris was considered as a coloniser and was probably not the cause of this fatal outcome. C. auris was identified with MALDI-TOF, with subsequent confirmation by sequencing of the internal transcribed spacer (ITS) region. Antifungal susceptibility testing with Sensititre YeastOne™ (Trek Diagnostics Systems) showed minimum inhibitory concentrations (MICs) of 256, 4, 1, 0.06, 0.12, 0.06 µg/ml for fluconazole, voriconazole, amphotericin B, caspofungin, anidulafungin and micafungin, respectively. The patient was placed on contact precautions, and her room was cleaned with a chlorine-based solution and an active oxygen-based surface disinfectant after discharge. Multiple environmental samples obtained from the room after cleaning were all negative for C. auris.
We retrospectively analysed the national cohort of candidaemia of the Fungal Infection Network of Switzerland (FUNGINOS) comprising 2102 Candida bloodstream isolates collected from 25 Swiss hospitals between 2004 and 2013. C. auris was not recovered during this period. All isolates belonging to species closely related to C. auris, which may have been potentially misidentified (four Candida famata, two unspecified Candida spp. and five Saccharomyces cerevisiae), were retrospectively tested by mass spectrometry (matrix-assisted laser desorption ionisation-time of flight, MALDI-TOF) for confirmation.
Recommendations for microbiology laboratories
Accurate and rapid identification of C. auris is crucial. C. auris is misidentified by classical biochemical methods. Vitek 2 YST (BioMérieux) and Phoenix (BD Diagnostics) cannot distinguish it from other Candida of the haemulonii complex, C. famata, C. lusitaniae and C. sake. API-20C AUX (BioMérieux) misidentified it as Rhodotorula glutinis [8, 9]. It can be correctly identified by sequencing the D1-D2 region of the 28S rDNA or by a qPCR targeting a specific rDNA region of C. auris [10, 11].
Accurate and fast identification is also achieved with MALDI-TOF, either the Biotyper (Bruker) or Vitek-MS (BioMérieux) systems, but only the “research use only” (RUO) libraries contain C. auris spectra (the FDA-approved IVD version does not) [8]. Some difficulties in obtaining a high score with direct deposit of C. auris on the MALDI plate when using the Biotyper have been reported [9]. Complete extraction following the manufacturer’s instructions is needed, and several deposits are recommended to obtain better results. Additionally, the use of a homemade database containing more spectra of C. auris significantly improves the identification results [12].
Recommendations for infection control and prevention
The potential of C. auris for inter-human transmission and nosocomial outbreaks is unusual for a fungus, and may be partly explained by its ability to form biofilms and survive on dry or moist surfaces [4]. High rates of candidaemia, persistent patient colonisation and persistence in the environment despite adequate infection control measures were the hallmarks of the C. auris outbreaks in the UK and Spain [6, 7]. Therefore, effective infection control strategies are crucial to prevent the emergence and spread of this pathogen, especially in intensive care units. The decision to establish a systematic C. auris screening policy should be assessed by each hospital on the basis of the local epidemiology. A listing of preventive measures that can be recommended in a country of very low prevalence, such Switzerland, is presented in table 1. We currently suggest targeted screening of patients with (1) documented C. auris infection or colonisation in the past, (2) previous contact with a known C. auris case, or (3) a recent stay in a hospital where C. auris is endemic. Importantly, each institution should prepare to deal with an emerging C. auris outbreak by establishing protocols for screening and disinfection procedures that can be applied as soon as a case of C. auris infection or colonisation is detected. Screening should involve swabbing axilla and groin, which have been associated with the highest yield of detection [13], with the optional addition of other sites (e.g., nose and/or clinically relevant sites). Cultures can be performed directly on commercial chromogenic Candida agar plates, where C. auris produce colonies that usually appear white to rose or light purple (depending on the culture medium) after 48 hours of incubation at 37°C (fig. 1).
Table 1 Recommendations for the prevention and management of Candida auris.
|
Question
|
Subject
|
Measures
|
| Which patients should be screened for C. auris? |
Patients transferred from or with recent stay in hospital with endemic C. auris
Patients with previous C. auris isolation
Direct contact (roommate) of C. auris case |
Composite swab (axilla, groin ± nose ± specific clinical site)
Preemptive contact precautions and single room isolation (or patient cohorting) until documented negative screening*
|
| How to manage C. auris cases? |
Patients with C. auris isolated in clinical specimens |
Contact precautions and single room isolation (or patient cohorting) until documented negative screening*
Decolonisation protocol with daily chlorhexidine washes
Avoid or remove catheters if possible or consider protective chlorhexidine disks for catheter exit sites
Colonisation only: do not treat with systemic antifungals
Infection: treat with an echinocandin as first-line therapy. Reassess treatment according to antifungal susceptibility testing results |
| Which measures of decontamination should be applied for C. auris? |
Direct environment of C. auris case (room, shared equipment) |
Use of chlorine-based or active oxygen-based products with sporicidal activity (daily and at discharge)
Consider hydrogen peroxide vaporization at discharge |
In countries with a high prevalence or in the setting of nosocomial outbreaks, pre-culture at 40°C in selective Sabouraud broths with a high-salt content and dulcitol or mannitol as carbon source in accordance with the Centers for Disease Control and Prevention protocol is recommended [14].
Patients with C. auris should be isolated in a single-patient room with contact precautions. Strict adherence to hand hygiene is required. Equipment used for the infected/colonised patient should not be shared with other patients. Quaternary ammonium is not active against C. auris. Therefore, for surface cleaning, chlorine-based or active oxygen-based products with sporicidal activity (similar to those used against Clostridium difficile) should be used [15]. Decontamination of the room and medical equipment with hydrogen peroxide vapour after discharge of the patient has been performed during outbreaks [7].
Recommendations for clinical management of C. auris colonisation and infection
Treating C. auris colonisation with systemic antifungal agents is not recommended. Persistent skin colonisation is common and there are no well-established decolonisation protocols. Daily chlorhexidine washes are recommended, but their efficacy has not been demonstrated [7, 13]. For documented or suspected cases of C. auris infection, echinocandins represent the first-line treatment, with >90% of strains remaining susceptible. Resistance to fluconazole is present in most cases, while voriconazole and amphotericin B have variable activity [2, 10]. According to antifungal susceptibility testing results, these later drugs may be considered as second-line or salvage therapies.
Conclusions
The threat of C. auris is a serious consideration because of the virulence of this pathogen, its multi-resistant profile and its potential for nosocomial transmission and prolonged outbreaks, in particular among critically ill patients. Microbiology laboratories should be aware of the diagnostic challenges related to the identification of this pathogen. Infection control protocols for screening and management of C. auris infection/colonisation should be planned in order to anticipate outbreaks, which can rapidly become overwhelming and difficult to eradicate.
Acknowledgments
We acknowledge the Fungal Infection Network of Switzerland (FUNGINOS) for providing epidemiological data about Candida bloodstream infections in Switzerland.
The authors are indebted to the teams of the Laboratory of Bacteriology, Infectious Diseases Division and Critical Care Unit at HUG for their microbiology and clinical work-up, as well as Dominique Joubert for help with implementation of infection control measures.
We are grateful to Dominique Blanc and to Mathieu Fraschina (Service of Hospital Preventive Medicine, Lausanne University Hospital) for attentive review of the manuscript and for figure design, respectively.
Author contributions
AR and DN contributed equally to the work.
References
1
Lamoth
F
,
Lockhart
SR
,
Berkow
EL
,
Calandra
T
. Changes in the epidemiological landscape of invasive candidiasis. J Antimicrob Chemother. 2018;73(suppl_1):i4–13. doi:.https://doi.org/10.1093/jac/dkx444
2
Lockhart
SR
,
Etienne
KA
,
Vallabhaneni
S
,
Farooqi
J
,
Chowdhary
A
,
Govender
NP
, et al.
Simultaneous Emergence of Multidrug-Resistant Candida auris on 3 Continents Confirmed by Whole-Genome Sequencing and Epidemiological Analyses. Clin Infect Dis. 2017;64(2):134–40. doi:.https://doi.org/10.1093/cid/ciw691
3
Satoh
K
,
Makimura
K
,
Hasumi
Y
,
Nishiyama
Y
,
Uchida
K
,
Yamaguchi
H
.
Candida auris sp. nov., a novel ascomycetous yeast isolated from the external ear canal of an inpatient in a Japanese hospital. Microbiol Immunol. 2009;53(1):41–4. doi:.https://doi.org/10.1111/j.1348-0421.2008.00083.x
4
Lamoth
F
,
Kontoyiannis
DP
. The Candida auris Alert: Facts and Perspectives. J Infect Dis. 2018;217(4):516–20. doi:.https://doi.org/10.1093/infdis/jix597
5
Rudramurthy
SM
,
Chakrabarti
A
,
Paul
RA
,
Sood
P
,
Kaur
H
,
Capoor
MR
, et al.
Candida auris candidaemia in Indian ICUs: analysis of risk factors. J Antimicrob Chemother. 2017;72(6):1794–801. doi:.https://doi.org/10.1093/jac/dkx034
6Ruiz A. Epidemiology and clinical features caused by Candida auris in the setting of a prolonged outbreak [session S18]. In: program and abstracts of the 8th Trends in Medical Mycology (Belgrad, Serbia, Oct 6-9th 2017). 2017.
7
Schelenz
S
,
Hagen
F
,
Rhodes
JL
,
Abdolrasouli
A
,
Chowdhary
A
,
Hall
A
, et al.
First hospital outbreak of the globally emergingCandida aurisin a European hospital. Antimicrob Resist Infect Control. 2016;5(1):35. doi:.https://doi.org/10.1186/s13756-016-0132-5
8
Chowdhary
A
,
Sharma
C
,
Meis
JF
.
Candida auris: A rapidly emerging cause of hospital-acquired multidrug-resistant fungal infections globally. PLoS Pathog. 2017;13(5):e1006290. doi:.https://doi.org/10.1371/journal.ppat.1006290
9
Mizusawa
M
,
Miller
H
,
Green
R
,
Lee
R
,
Durante
M
,
Perkins
R
, et al.
Can Multidrug-Resistant Candida auris Be Reliably Identified in Clinical Microbiology Laboratories?
J Clin Microbiol. 2017;55(2):638–40. doi:.https://doi.org/10.1128/JCM.02202-16
10
Chowdhary
A
,
Anil Kumar
V
,
Sharma
C
,
Prakash
A
,
Agarwal
K
,
Babu
R
, et al.
Multidrug-resistant endemic clonal strain of Candida auris in India. Eur J Clin Microbiol Infect Dis. 2014;33(6):919–26. doi:.https://doi.org/10.1007/s10096-013-2027-1
11
Kordalewska
M
,
Zhao
Y
,
Lockhart
SR
,
Chowdhary
A
,
Berrio
I
,
Perlin
DS
. Rapid and Accurate Molecular Identification of the Emerging Multidrug-Resistant Pathogen Candida auris
. J Clin Microbiol. 2017;55(8):2445–52. doi:.https://doi.org/10.1128/JCM.00630-17
12
Bao
JR
,
Master
RN
,
Azad
KN
,
Schwab
DA
,
Clark
RB
,
Jones
RS
, et al.
Rapid, Rapid, Accurate Identification of Candida auris by Using a Novel Matrix-Assisted Laser Desorption Ionization–Time of Flight Mass Spectrometry (MALDI-TOF MS) Database (Library). J Clin Microbiol. 2018;56(4):e01700-17. doi:.https://doi.org/10.1128/JCM.01700-17
13
Tsay
S
,
Welsh
RM
,
Adams
EH
,
Chow
NA
,
Gade
L
,
Berkow
EL
, et al.; MSD. Notes from the Field: Ongoing Transmission of Candida auris in Health Care Facilities - United States, June 2016-May 2017. MMWR Morb Mortal Wkly Rep. 2017;66(19):514–5. doi:.https://doi.org/10.15585/mmwr.mm6619a7
14
Welsh
RM
,
Bentz
ML
,
Shams
A
,
Houston
H
,
Lyons
A
,
Rose
LJ
, et al.
Survival, Persistence, and Isolation of the Emerging Multidrug-Resistant Pathogenic Yeast Candida auris on a Plastic Health Care Surface. J Clin Microbiol. 2017;55(10):2996–3005. doi:.https://doi.org/10.1128/JCM.00921-17
15
Cadnum
JL
,
Shaikh
AA
,
Piedrahita
CT
,
Sankar
T
,
Jencson
AL
,
Larkin
EL
, et al.
Effectiveness of Disinfectants Against Candida auris and Other Candida Species. Infect Control Hosp Epidemiol. 2017;38(10):1240–3. doi:.https://doi.org/10.1017/ice.2017.162